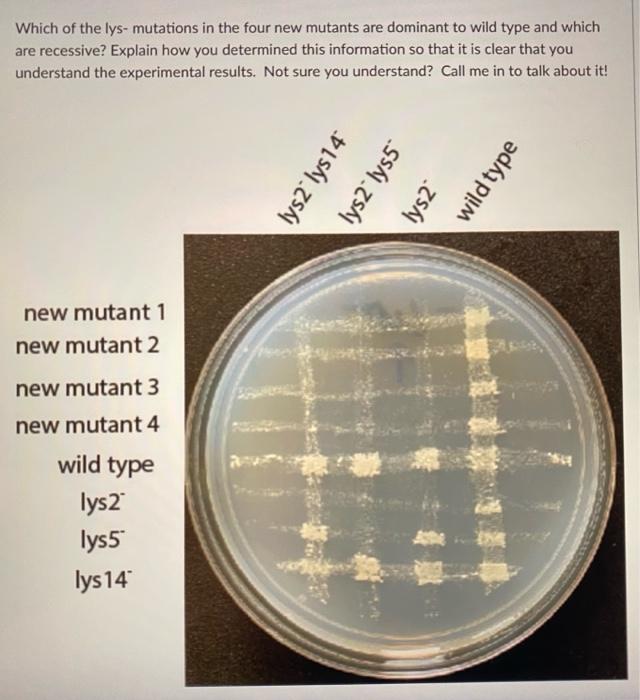

Dominant talk

🛑 👉🏻👉🏻👉🏻 FOR MORE INFORMATION, CLICK HERE 👈🏻👈🏻👈🏻
Katsumi Passionate Blowjob
Firm Round Titties
Hairy Mature Video Mature Women Video Mature Porno
Shaving A Milfs Muff
Avenue Kid
Open World Sex Games
Leanna Decker Freeones
Dominant talk






































204">203">200_.jpg">


w_750">f_auto/




















































800_CR200">50">1200">630_CLa%7C1200">630%7C41jycy8Z2HL.jpg%7C0">0">1200">630+107">79">402">402_PJAdblSocialShare-Gradientoverlay-smallasin-0to70">TopLeft">0">0_PJAdblSocialShare-AudibleLogo-Large">TopLeft">576">270_OU01_ZBLISTENING%20ON">593">216">52">500">AudibleSansMd">30">255">255">255_PJAdblSocialShare-PodcastIcon-Small">TopLeft">1094">50_ZBDominant%20Conversation%3A%20...">106">519">48">404">AudibleSansMd">24">255">255">255.jpg">